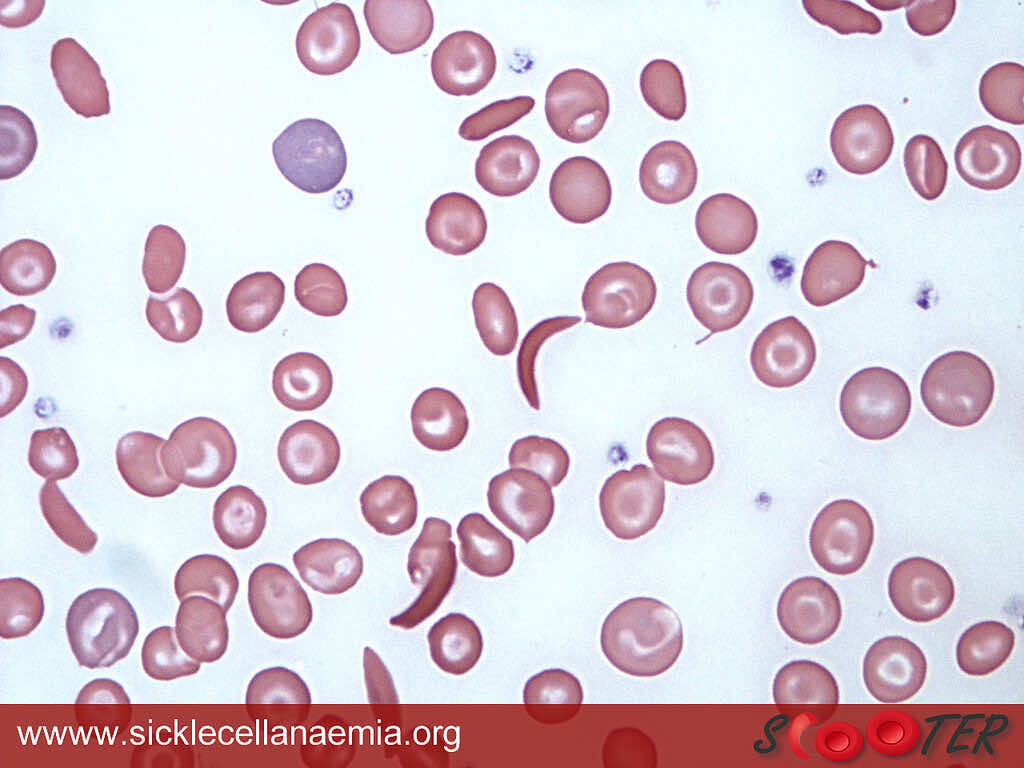
Sickle cell shapes

SICKLE CELL ANAEMIA: THE STORY OF ONE MISSHAPEN CELL
Anaemia is a common disorder of the blood, in which there is either a deficiency of red blood cells or haemoglobin in the blood, leading to symptoms such as excess fatigue and pale colour. There are many different types of anaemias, including iron, B12 or folate deficiency anaemias, which your GP can diagnose by performing simple private blood tests. But one type of anaemia you may not be so familiar with is sickle cell anaemia, or sickle cell disease. Similarly, these affect those vital red blood cells, but with slightly different symptoms.
What is sickle cell disorder?
Sickle cell disorder is a genetic blood disorder, in which there is abnormal haemoglobin in red blood cells. Haemoglobin is the protein which gives blood its red colour and allows red blood cells to carry oxygen around the body. In sickle cell disorder, the abnormal haemoglobin causes the red blood cells to change shape and become sticky, resulting in them blocking small blood vessels. When this prevents blood reaching a particular organ, the result is an extremely painful episode called a sickle cell crisis.
People with Sickle Cell Disorder have a number of sickle/crescent-shaped red blood cells, instead of the healthy circular shape
Sickle cell pain crises triggers include:
- Stress
- Cold temperatures
- Dehydration
- Infection
- High altitudes.
People with sickle cell disorder are also a greater risk of stroke as well as damage to organs like the spleen, liver and kidneys (more on a liver function test and kidney tests).
Who gets Sickle Cell disorders?
Sickle cell disorder is genetically inherited - specifically an autosomal recessive disorder. This means, you must have two copies of the gene for sickle cell to have the disorder. In other words, you must inherit a sickle cell gene from both your parents in order to have the disorder.
If you have only one copy of the gene for sickle cell, i.e. you inherited it from one parent, you are a carrier of the disorder and are said to have sickle cell trait. People with sickle cell trait do not have the symptoms of sickle cell disorder and will never develop sickle cell disorder, however, they may experience problems with medications like anaesthetics and may experience pain at high altitudes.
Inheriting Sickle Cell disorders:
People with sickle cell trait may also pass on the sickle cell gene to their children.
Chances of children inheriting sickle cell:
-
If you have sickle cell trait and your partner does not, there is a:
-
0% chance of your children having sickle cell disorder
-
1 in 2 (50%) chance of any given child having sickle cell trait
-
-
If you and your partner both have sickle cell trait, there is a:
-
1 in 4 (25%) chance of any given child having sickle cell disorder
-
1 in 2 (50%) chance that they will have sickle cell trait
-

Autosomal recessive inheritance pattern of Sickle Cell disorder
1 in 76 babies born in the UK carry sickle cell trait. The gene for sickle cell is more commonly found among people of Sub-Saharan African origin, with 1 in 4 West Africans and 1 in 10 African-Caribbeans having sickle cell trait. The gene for sickle cell is also found among people from the Mediterranean, Asia and the Middle East.
Being sickle cell trait (a carrier of the gene) is somewhat protective against the malaria parasites which live in red blood cells, and it is thought that this may explain why the sickle cell gene is more common in regions where malaria is common.
Sickle Cell Diagnosis
Sickle cell trait and sickle cell disorder can be identified by a simple blood test. This is offered at London Doctors Clinic, whereby during a consultation with a GP at any of our seven central London clinics, our GP can council you through the process, and take the relevant blood sample. This is then sent off to our lab for analysis, with result available in just 4 days. Please note, we can not do amniocentesis investigations for unborn babies, but could provide a specialist referral to the relevant private clinic to facilitate this.

One simple blood test can confirm if someone has sickle cells or has sickle trait
The government Sickle cell and thalassaemia screening programme offers screening to:
-
To all newborn babies at 5 days old (heelprick test)
-
To all pregnant women early in pregnancy (ideally by 10 weeks). This type of screening (antenatal screening) identifies mothers who have the sickle cell trait. If the mother is found to have the trait, the baby’s father is offered a screening test.
Managing Sickle Cell Disorders
Currently, the only cure for the disorder is a bone marrow transplant, however very few people manage to find a suitable donor. Once diagnosed with sickle cell disorder, you will be treated with a specialist doctor or team who can advise you on the best steps to take to avoid crisis triggers and maintain good health.
The main aim of sickle cell disorder medication is to manage symptoms. For example:
-
Painkillers are prescribed during a crisis
-
Hydroxycarbamide (hydroxyurea) may be prescribed to people with frequent sickle cell crises
-
Antibiotics and vaccinations may be given to people with damage to the spleen
- Antibiotics may also be given as prophylaxis, for patients whose crises are triggered by infections
Genetic counselling, antenatal screening and pregnancy support is also available for people with sickle cell disorder or sickle cell trait who plan to have children.
If you think you or your partner may have sickle cell trait, why not book an appointment today at any London Clinic of our 7 central London locations? We do same day appointments and can facilitate the relevant blood tests for you, with results in just 4 days with the most affordable private doctors in London!